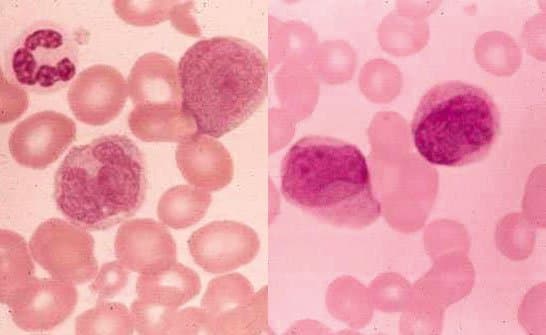
لوسمی حاد میلومنوسیتیک  M4 -AML
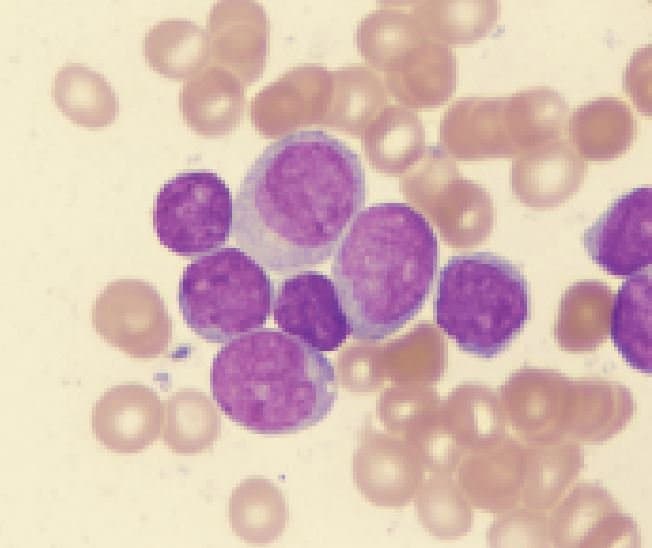
لوسمی حاد میلومنوسیتیک  M4 -AML
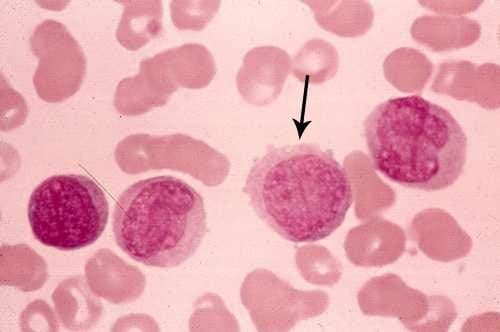
لوسمی حاد میلومنوسیتیک  M4 -AML

لوسمی حاد میلومنوسیتیک M4 -AML
لوسمی حاد میلومنوسیتیک M4 -AML
مخلوطی از منوبلاستها (بزرگتر از میلوبلاست، سیتوپلاسم فراوان، واجد تعداد متغیری گرانول، هسته گرد یا بیضی، کروماتین ظریف، یک یا چند هستک واضح) و میلوبلاستها دیده میشود. آئور راد در بیش از۵۰% موارد وجود دارد.
در M4 تعدادی میلوبلاست همراه با حدود ۲۰% یا کمی بیشتر منوبلاست و پرومنوسیت یافت میشود و لذا به M4 لوسمی میلومنوبلاستیک حاد AMML میگویند.
در این نوع لوسمی افزایش لیزوزیم سرم و ادرار دیده می شود و در درصد کمی از مبتلایان افزایش خفیف تا متوسط ائوزینوفیلهای خون دیده میشود و از نظر سیتوژنتیک در این بیماران معکوس شدن کروموزوم ۱۶ را شاهد هستیم.
در این بیماری تورم لثه همراه با ندولهای پوستی مشاهده میشود. در این لوسمی رنگ آمیزی سودان بلاک B، پراکسیداز، کلرواستات استراز و استراز غیر اختصاصی مثبت است.